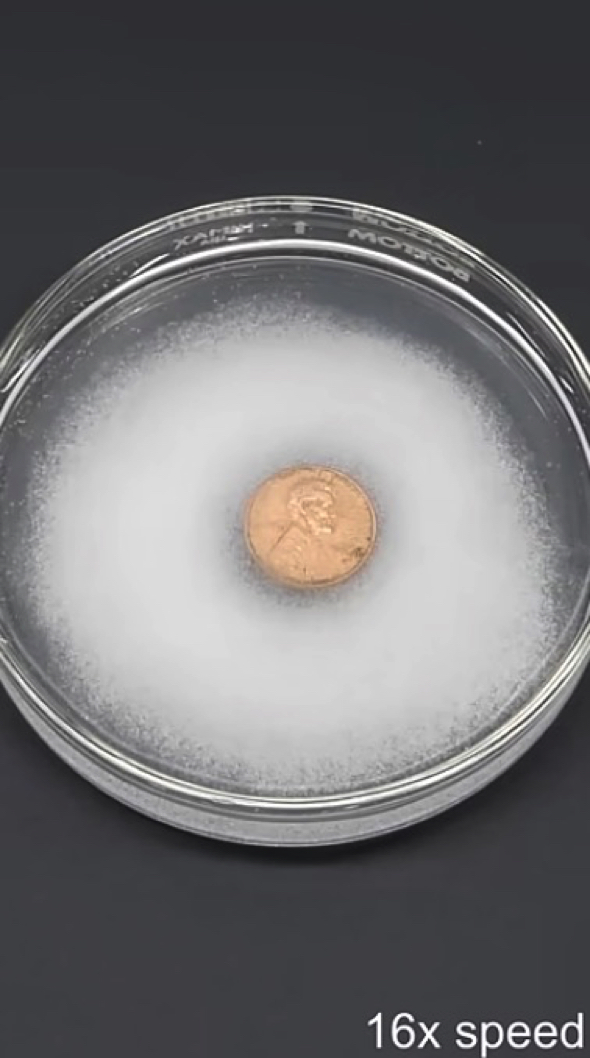
ブロンズ硬貨をゴールドに変える

これが本物の金だったら……。
銅メッキの1セント硬貨をゴールドに変える実験動画がYouTubeに投稿され、300万回以上再生されています。

ブロンズ色の1セント硬貨
銅がゴールドに?
動画を投稿したのはカナダ出身の化学実験系YouTuberのナイル・レッドさん(@NileRed)です。これまでにも白い炎を作る実験動画(関連記事)など、興味深い動画を多数投稿して話題を集めています。
今回の動画では化学物質を使って、亜鉛に銅メッキをしたブロンズ色の米1セント硬貨をゴールド色に変える実験を行っています。
1セント硬貨の汚れを取る
まず、ナイルさんは付着した汚れを落とすために、硬貨を塩と酢を混ぜた溶液に浸しました。汚れが落ちるまでの間に排水管のクリーナーとしても使われる水酸化ナトリウムを水で溶かし、その中に亜鉛金属を加えます。
次に汚れが落ちて綺麗になった硬貨を一旦水で洗い流し、亜鉛金属の入った溶液にしばらくの間浸します。すると硬貨は亜鉛金属でコーティングされ、ブロンズからシルバーに色が変化しました。

ゴールド色の1セント硬貨
シルバーからゴールドへ
そしてここからいよいよ終盤。溶液から取り出した硬貨をホットプレートで熱すると、シルバーからゴールドへと色が変化。ナイルさん曰く、硬貨の見た目はゴールドのように見えるものの、本物の金ではなく、実際には熱によって亜鉛コーティングが銅と結合して形成された真鍮とのこと。
それでも、金色に輝く硬貨はなんだか純金でできた硬貨を見てるようで、ワクワクする気持ちを抑えられなくなりそうです。ちなみにナイルさんは、アメリカの1セント硬貨を使用して実験していますが、日本では貨幣の加工は法律で禁止されているので、日本の貨幣ではマネしないようにしてくださいね。
ナイルさんのYouTubeチャンネル「NileRed」には、記事執筆時点で820万人以上の登録者がおり、他にもパープルゴールドを作ったり使い古しのジュエリーから純金の延べ棒を作る興味深い実験動画が投稿されています。